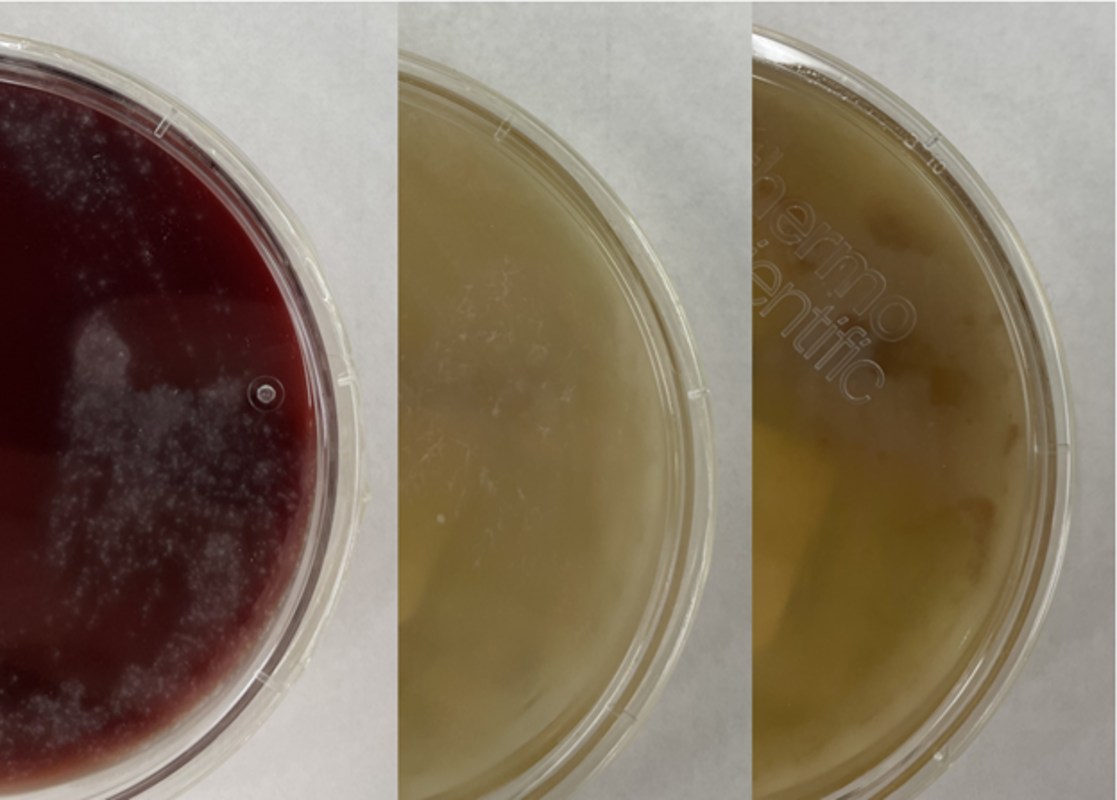

Пациент среднего возраста со сложной историей болезни поступил в отделение неотложной помощи с жалобами на одышку и кашель.
Пациент недавно был госпитализирован по поводу внутрибольничной пневмонии и выписан с антибиотиками 10 дней назад. Однако у пациента сохранялся сухой кашель, температура и одышка. При новом поступлении была отмечена гипотония, а анализы показали повышенный уровень лейкоцитов (14,7), лактата 7,3, proBNP - 852 и прокальцитонина - 4,62.
Бактериальные культуры крови не дали роста. Рентген грудной клетки показал ухудшение консолидации левой нижней доли с распространением на левую верхнюю долю, по сравнению с рентгеном при предыдущей госпитализации. Была проведена бронхоскопия и бронхоальвеолярный лаваж был отправлен на окраску по Граму, культуру аэробных бактерий и грибков. Окраска по Граму и бактериальная культура были отрицательными. Однако флюорохромное окрашивание показало множество крупных почкующихся дрожжевых форм, наиболее предположительно Blastomyces dermatitidis. Культура образца ткани легкого (изображение 1), окраска по Граму (изображение 2) и гистопатология (изображение 3) подтвердили идентификацию Blastomyces dermatitidis. Пациент скончался до получения результатов. Патологоанатомические снимки легких показаны на изображении 4.
Изображение 1. Рост грибков на чашке с Сабуро декстрозным агаром.

Изображение 2. Окрашивание по Граму образца ткани левой нижней доли легкого, демонстрирующее почкующиеся грибки.

Изображение 3. Окрашивание срезов левой нижней доли легкого с демонстрацией почкующихся грибков.

Изображение 4. Патологоанатомические снимки легких с гепатизацией левой нижней доли и милиарной консолидацией в правом легком.
Обсуждение
Blastomyces dermatitidis - это диморфный грибок, встречающийся в почве и гниющей древесине. Часто встречается в районах, расположенных вблизи источников воды, таких как озеро, река или ручей. Инфицирование человека происходит при вдыхании конидий. Бластомикоз (он же болезнь Гилкриста) может вызывать широкий спектр клинических проявлений. Наиболее поражаемыми органами являются легкие и кожа. Бластомикоз костей, мочеполовой системы, центральной нервной системы и диссеминированный бластомикоз также могут встречаться, но с меньшей частотой.
В отличие от оппортунистических грибковых патогенов, таких как H. capsulatum, C. immitis и C. neoformans, B. dermatitidis с меньшей вероятностью вызывает заболевания у иммунокомпрометированных пациентов по сравнению с неиммунокомпрометированными. Однако заболевание протекает тяжелее, в более выраженной форме, с более высокой смертностью.
Хотя в нашем случае рост грибков происходил в течение 2 дней, Blastomyces - медленно растущий грибок, мицелиальные формы которого созревают через 14-21 день. В подозрительных случаях культуры должны храниться до 8 недель. Кроме того, Blastomyces следует культивировать как можно скорее, поскольку он плохо выживает в образцах.
Морфологически колония Blastomyces выглядит как плесень, белая, колючая и "ватная" при температуре 25-30 °C. Однако при температуре 35-37 °C колонии выглядят как дрожжи, морщинистые, имеющие коричневый или восковой цвет. Микроскопически при 37 °C Blastomyces выглядят как круглые или овальные клетки с преломляющимися и толстыми клеточными стенками и размером 8-15 мкМ в диаметре. Каждая дрожжевая клетка производит только одну, широкую (4-5 мкМ) почку. При температуре 25-30 °C образуются септальные гифы с короткими или длинными конидиеносцами. На вершине прикрепляются конидии круглой или грушевидной формы, напоминающие леденцы (изображение 5).

Изображение 5. Сферические, овальные или пириформные конидии, поднимающиеся из воздушных гиф.
История недавней поездки в эндемичные районы или проживания в них обычно вызывает подозрение с учетом клинических данных. Существуют различные вспомогательные методы диагностики B. dermatitidis, включая культуру, цитологический мазок, гистопатологию, анализ мочи на антиген, анализ сыворотки на антиген, анализ сыворотки на антитела и молекулярные методы.
Анализ сыворотки на антитела обладает высокой степенью перекрестной реактивности с другими эндемичными микозами. Анализ сыворотки и мочи на антигены имеет чувствительность 89 % и специфичность 79 % и полезен для диагностики, мониторинга лечения и выявления рецидивов. Прямая визуализация характерной дрожжевой формы с широким распространением на цитологическом мазке респираторных секретов или образцов тканей с использованием флюорохромного окрашивания расценивается как предположительный диагноз и достаточна для начала противогрибковой терапии. Однако отрицательный результат в мазке не может исключить диагноз из-за недостаточной чувствительности. Для выявления B. dermatitidis были разработаны анализы на основе ПЦР, однако, несмотря на их перспективность, их целесообразность не подтверждена.
Только гистопатология и культура могут помочь поставить окончательный диагноз. Окрашивание кислотой Шиффа и метенаминовым серебром Грокотта полезно для выделения дрожжевой формы в срезах тканей. При культивировании наблюдение характерного морфологического и микроскопического вида очень способствует постановке диагноза. Однако может потребоваться подтверждение с помощью хемилюминесцентного ДНК-зонда.
В зависимости от тяжести и локализации инфекции в лечении могут быть использованы флуконазол, итраконазол, вориконазол или амфотерицин В.

